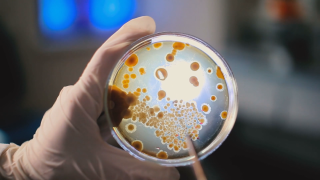

Кристина Налбантова
Кристина Налбантова е репортер в bTV Новините с ресор здравеопазване и социални теми.
Родена е в Бургас, където завършва Английската гимназия „Гео Милев“. Придобива бакалавърска степен по журналистика в Софийски университет „Св. Климент Охридски“ и магистратура със специалност „Реклама и публични комуникации“ отново в Алма матер.
Трупа медиен опит в различни информационни сайтове, както и в международния отдел на телевизия „Европа“.
За пръв път прекрачва прага на bTV като стажант-репортер през 2017 година. Макар да вярва, че целта на журналистиката е да дава отговори и разрешава обществени проблеми, най-важни за нея са хората, на които е успяла да помогне и историите с щастлив край.
-
 Препаратът на "Янсен" - без ограничения в употребата му у нас (ОБЗОР)
Препаратът на "Янсен" - без ограничения в употребата му у нас (ОБЗОР) -
 Излизаме от третата вълна: Щабът предупреждава за спазване на мерките (ОБЗОР)
Излизаме от третата вълна: Щабът предупреждава за спазване на мерките (ОБЗОР) -
 Откривателите на българската мутация на COVID-19: Кои са учените, които я изолираха?
Откривателите на българската мутация на COVID-19: Кои са учените, които я изолираха? -
 „АстраЗенека“ и тромбозите: Експерти в задочен спор за страничните реакции
„АстраЗенека“ и тромбозите: Експерти в задочен спор за страничните реакции -
 Учени от БАН: Българският щам на COVID-19 е леко изменен британски вариант
Учени от БАН: Българският щам на COVID-19 е леко изменен британски вариант -
Третата вълна: Здравните власти наблюдават трайно намаляване на заразените (ОБЗОР)
Третата вълна: Здравните власти наблюдават трайно намаляване на заразените (ОБЗОР) -
 Една пета от персонала и потребителите на социалните домове у нас са ваксинирани
Една пета от персонала и потребителите на социалните домове у нас са ваксинирани -
 Ваксинацията с „АстраЗенека“ продължава, здравните власти отчитат по-слаб интерес
Ваксинацията с „АстраЗенека“ продължава, здравните власти отчитат по-слаб интерес -
 Как ще се спазят противоепидемичните мерки при предаване на изборните документи
Как ще се спазят противоепидемичните мерки при предаване на изборните документи -
 България ще получи над 1,25 млн. допълнителни ваксини на „Пфайзер“ (ОБЗОР)
България ще получи над 1,25 млн. допълнителни ваксини на „Пфайзер“ (ОБЗОР) -
 Разхлабват поетапно противоепидемичните мерки (ОБЗОР)
Разхлабват поетапно противоепидемичните мерки (ОБЗОР)


